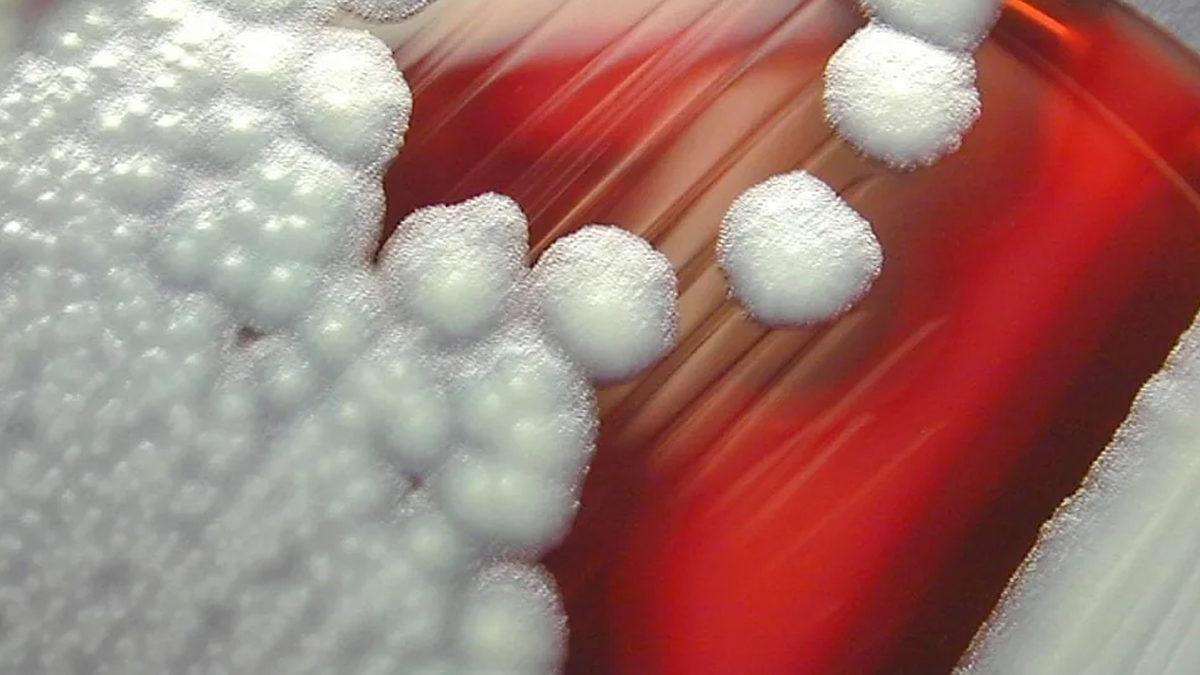
Soframızdan Eksik Olmayan Pirinç, Neden Dünyada İnsanları En Çok Zehirleyen Gıdalardan Biri?

Evet, yanlış duymadınız: Basit bir tabak pilav, doğru şekilde saklanmadığında ve yeniden ısıtıldığında sizi zehirleyebilir.
Sık tüketilen ama yeterince dikkat edilmediğinde gıda güvenliğini ciddi tehlikeye sokan pilav hakkında bazı gerçekleri gün yüzüne çıkaralım.
Tek bir sorumlusu var, o da Bacillus cereus bakterisi.
Bazı yiyeceklerde, toprakta ve deniz sürüngenlerinde bulunan Bacillus cereus bakteri sporları, oldukça dirençli bir yapıya sahip. Pilavı ilk pişirirken sporlar hayatta kalırken oda sıcaklığında bırakılırsa toksin üretiyor.
Tekrar ısıttığımızda ise hücreleri öldürsek bile toksinleri yok etmiyoruz ve bu da sağlığımızı tehdit eden bir unsur oluyor.
Çoğu insan toksinlerin bir miktarıyla baş edebiliyor ancak Bacillus cereus bakterisi tehlikeyi bölgeye girdiğinde bizi hasta ediyor.
Gıda zehirlenmelerinde sıkça karşılaşılıyor.

Uzun süre bekletildiğinde, yeniden ısıtıldığında ya da hızla soğutulmadığında pilavın zehirlenmeye yol açması, gıda güvenliği araştırmalarında önemli bir detay.
Dünya Sağlık Örgütü (WHO) ve Amerikan Gıda ve İlaç Dairesi (FDA) gibi kurumlar, Bacillus cereus'un en yaygın gıda zehirlenmesi etkenlerinden biri olduğunu ve pirinç gibi gıdalarda hızla çoğalabildiğini belirtiyor.
Gıda kaynaklı zehirlenmelerin %2 ila %5'i Bacillus cereus nedeniyle meydana geliyor ve bunun en çok pilav, makarna ve patates gibi gıdalardan kaynaklandığı biliniyor. Yani nişasta ve bu bakteri için ayrılmaz ikili diyebiliriz.
Peki etkileri neler, sağlımızı nasıl tehdit ediyor?

Bacillus cereus nedeniyle zehirlenmeye başlıyorsanız bunun belirtilerini 6 ila 12 saat içerisinde fark edersiniz. Mide bulantısı, kramp ve çok fazla kusma yaygın belirtiler arasında. Eğer bakteriler bağırsağınızda çoğalıp toksin üretirse de şiddetli ishal de belirtilere eklenebilir.
Bundan ilerisi ise çok yaygın değil yani Bacillus cereus sebebiyle ölme riskiniz çok az. Ya da şöyle diyelim Bacillus cereus’un, organ yetmezliğine hatta ölümle sonuçlanan ciddi enfeksiyonlara neden olduğu vakalar olsa da bunlar son derece nadir.
Pilav zehirlenmesini nasıl önleyeceğiz?

- Hızlı soğutma: Pişirilen pilavı oda şeklinde en fazla iki saat bekletin ve daha sonra hızla soğutun. Soğutma işlemi için pilavı yayvan bir kaba koyarak ya da ufak kaplara bölerek buzdolabına koyabilirsiniz. Böylece bakterilerin çoğalmasını engelleyebilirsiniz.
- Tekrar ısıtma sınırlamaları: Pilavı bir kez ısıttıktan sonra hemen tüketin ve tekrar ısıtmaktan kaçının. Her ısıtma işleminde Bacillus cereus sporlarının toksin üretme riski artar.
- Saklama süresi: Pilavı en fazla 24 saat saklamaya özen gösterin. Bu süreden sonra pilavda bakteri ve toksin oluşma riski artar.
- Dondurmak: Pilavın uzun süre saklanması gerekiyorsa buzdolabının yerine derin dondurucuyu tercih edin. Dondurucu, üreme faaliyetlerini durdurarak gıdaları daha güvenli hâle getirir.
Yemek hazırlarken dikkatli olarak hem sağlığınızı koruyabilir hem de pilav gibi masum görülen yiyeceklerin olası risklerini azaltabilirsiniz.

